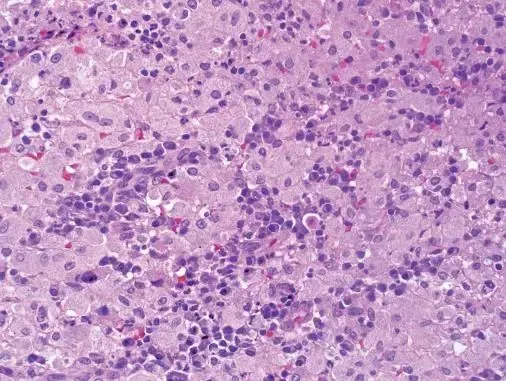
浸润型肺结核难治吗_浸润型肺结核严重吗_肺浸润型肺结核

浸润型肺结核严重吗-浸润型肺结核:低调的肺部窃贼,破坏力不容小觑
时间:2024-08-24 来源:网络整理 人气:
哎呀,说到这个浸润型肺结核,我的心都揪起来了!这可不是什么小打小闹的病,它悄悄地、慢慢地侵蚀着我们的肺,就像个狡猾的窃贼,总是在你不注意的时候下手。
你知道吗?这种类型的肺结核,它不像那些一发病就大张旗鼓的家伙,它低调得很,但破坏力一点不小。它会让你的肺部出现一片片的阴影,就像是乌云密布的天空,让人心里直发毛。而且,它还特别喜欢在年轻人和免疫力低下的人身上“安家”,真是让人防不胜防。

更可怕的是,这种病有时候还特别“懒”,不怎么爱动,所以在早期的时候,你可能根本感觉不到什么异常。但是,一旦它开始“活跃”起来,那可就是另一番景象了。咳嗽、咳痰、发热、盗汗……一系列的症状让人痛苦不堪。而且,如果治疗不及时或者不彻底,它还可能会变成慢性病,长期困扰着你,甚至有可能传染给家人和朋友,这。
tokenpocket最新v1.8.7版下载:https://klbeyey.com/software/326.html
作者 克莱贝尔系统
相关推荐
教程资讯
教程资讯排行













